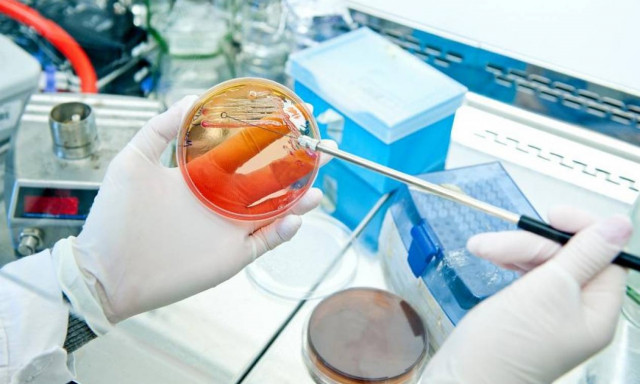
Αμερικάνικη γκάφα: Στρατιωτική εγκατάσταση έστειλε ενεργό βάκιλο του άνθρακα σε εργαστήρια

ΑΝΘΡΑΚΑΣ

ΗΠΑ: Ενεργός άνθρακας είχε σταλεί από τον αμερικανικό στρατό και στην Αυστραλία
ΚΟΣΜΟΣ
·
29.05.2015 - 19:58
Ενεργός άνθρακας εντοπίστηκε σε ένα δείγμα του 2008 που είχε σταλεί στην Αυστραλία από τις ίδιες εγκαταστάσεις των αμερικανικών ενόπλων δυνάμεων που διαπιστώθηκε αυτήν την…
Αμερικάνικη γκάφα: Στρατιωτική εγκατάσταση έστειλε ενεργό βάκιλο του άνθρακα σε εργαστήρια
ΚΟΣΜΟΣ
·
28.05.2015 - 02:50
Από στρατιωτική εγκατάσταση στην πολιτεία Γιούτα στάλθηκαν κατά λάθος ενεργά δείγματα βακίλων του άνθρακα σε ιδιωτικά εργαστήρια σε εννιά πολιτείες των ΗΠΑ αλλά και σε…

Δεν περιείχε άνθρακα ο φάκελος που εστάλη στην Εισαγγελία
ΕΛΛΑΔΑ
·
22.04.2015 - 21:37
Αρνητική ήταν η μοριακή διερεύνηση του δείγματος στον βάκιλο του άνθρακα που εστάλη την Τετάρτη (22/4/2015) στην Εισαγγελία Αθηνών.

Το Philae εντόπισε άνθρακα στον 67P
ΤΕΧΝΟΛΟΓΙΑ
·
20.11.2014 - 21:02
Μπορεί το ρομπότ Philae να... ξεκουράζεται πάνω στον κομήτη 67P, αφού έχει σταματήσει να εκπέμπει, ωστόσο οι μέχρι τώρα πληροφορίες που έχει στείλει αποδεικνύονται υπερπολύτιμες!

Πολωνία: Η ασθένεια του άνθρακα εντοπίστηκε σε νεκρό άλογο
ΚΟΣΜΟΣ
·
08.07.2014 - 22:45
Από την ασθένεια του άνθρακα έπασχε ένα άλογο που βρέθηκε νεκρό στην ανατολική Πολωνία, κοντά στα σύνορα της χώρας με την Ουκρανία, ανέφερε μια ντόπια…

Ουγγαρία: Συναγερμός για πιθανά κρούσματα της νόσου του άνθρακα
ΚΟΣΜΟΣ
·
04.07.2014 - 11:34
Κρούσμα της θανατηφόρου, σε κάποιες περιπτώσεις, νόσου του άνθρακα, εντοπίστηκε σε κατεψυγμένο βόειο κρέας στην ανατολική Ουγγαρία και πέντε άνθρωποι βρίσκονται υπό παρακολούθηση στο νοσοκομείο…

Τουλάχιστον 86 επιστήμονες ενδέχεται να εκτέθηκαν στο βακτήριο του άνθρακα!
ΚΟΣΜΟΣ
·
20.06.2014 - 18:31
Η αμερικανική κυβέρνηση ανακοίνωσε σήμερα ότι συνολικά 86 επιστήμονες και άλλοι εργαζόμενοι σε ομοσπονδιακά εργαστήρια βιοτεχνολογίας είναι πιθανόν να εκτέθηκαν στο βακτήριο του άνθρακα επειδή…

Δύο θάνατοι αγελάδων από άνθρακα στις Φέρες
ΕΛΛΑΔΑ
·
08.06.2014 - 09:09
Δύο θάνατοι ζώων από μόλυνση άνθρακα στην περιοχή των Φερών Έβρου κινητοποίησε τις αρμόδιες κτηνιατρικές υπηρεσίες του νομού και της Περιφέρειας Ανατολικής Μακεδονίας και Θράκης.

Αύξηση της παγκόσμιας ενεργειακής ζήτησης κατά 50% έως το 2030
ΟΙΚΟΝΟΜΙΑ
·
22.10.2013 - 17:00
Αύξηση σχεδόν 3% κατά μέσο όρο τον χρόνο αναμένεται να παρουσιάσει η παγκόσμια ενεργειακή ζήτηση κατά τη διάρκεια της τρέχουσας αλλά και της επόμενης δεκαετίας.…






